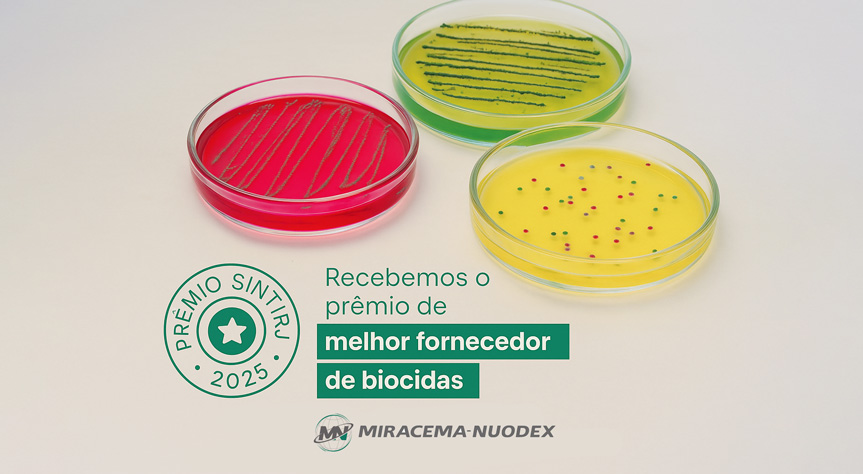

Miracema-Nuodex was elected the best biocide supplier at the SINTIRJ 2025 Awards.
This result is a reflection of continuous work, based on innovation, technical quality and partnership with our clients.
Our biocides are developed to ensure microbiological efficiency, safety and stability in various industrial applications. We thank our partners for their trust and for sharing our journey. Congratulations to SINTIRJ for organizing the event!
🔗 Visit the SINTIRJ website
🔗 See details of Dinner 2025